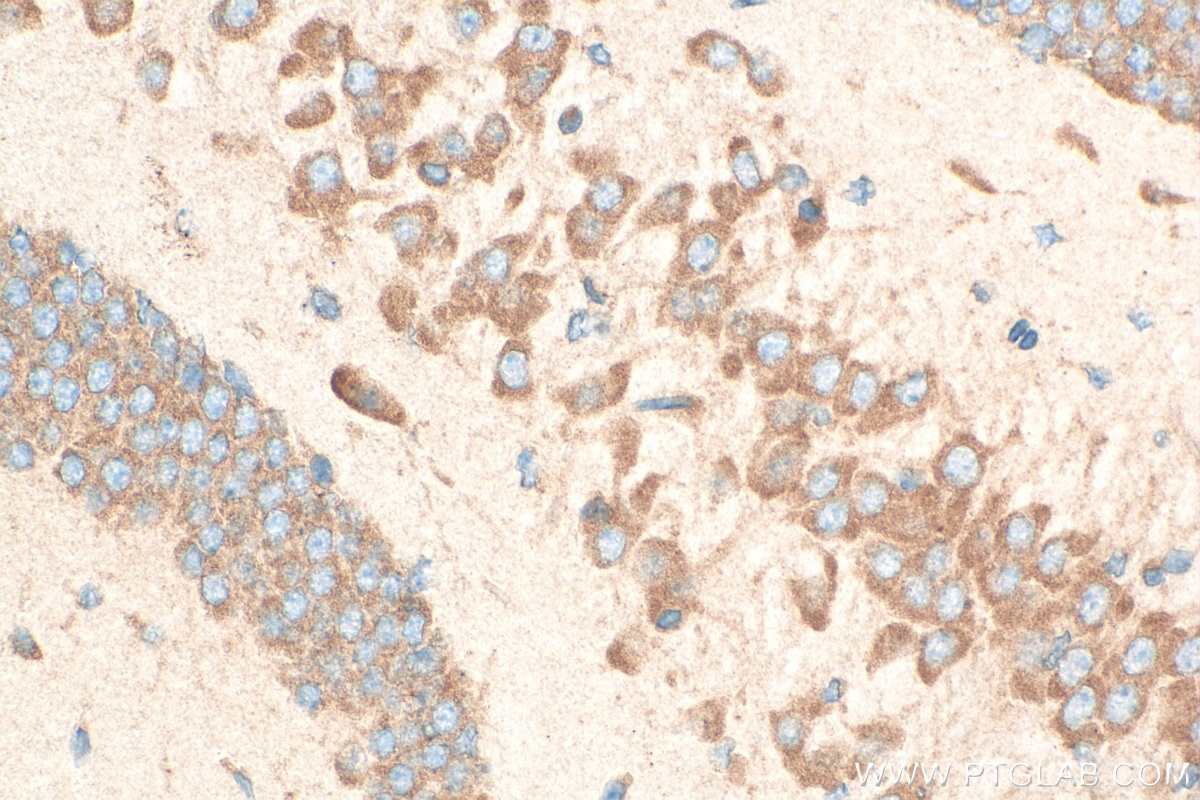
Immunohistochemistry (IHC) staining of mouse brain tissue using RPS12 Polyclonal antibody (16490-1-AP)

Tested Applications
| Positive WB detected in | NIH/3T3 cells, HeLa cells, HepG2 cells, MCF-7 cells |
| Positive IP detected in | HeLa cells |
| Positive IHC detected in | mouse brain tissue Note: suggested antigen retrieval with TE buffer pH 9.0; (*) Alternatively, antigen retrieval may be performed with citrate buffer pH 6.0 |
| Positive IF/ICC detected in | HepG2 cells |
Recommended dilution
| Application | Dilution |
|---|---|
| Western Blot (WB) | WB : 1:1000-1:4000 |
| Immunoprecipitation (IP) | IP : 0.5-4.0 ug for 1.0-3.0 mg of total protein lysate |
| Immunohistochemistry (IHC) | IHC : 1:200-1:800 |
| Immunofluorescence (IF)/ICC | IF/ICC : 1:200-1:800 |
| It is recommended that this reagent should be titrated in each testing system to obtain optimal results. | |
| Sample-dependent, Check data in validation data gallery. | |
Published Applications
| KD/KO | See 1 publications below |
| WB | See 11 publications below |
| IHC | See 2 publications below |
| IF | See 2 publications below |
Product Information
16490-1-AP targets RPS12 in WB, IHC, IF/ICC, IP, ELISA applications and shows reactivity with human, mouse, rat samples.
| Tested Reactivity | human, mouse, rat |
| Cited Reactivity | human, mouse, drosophila |
| Host / Isotype | Rabbit / IgG |
| Class | Polyclonal |
| Type | Antibody |
| Immunogen |
CatNo: Ag9615 Product name: Recombinant human RPS12 protein Source: e coli.-derived, PGEX-4T Tag: GST Domain: 1-132 aa of BC017321 Sequence: MAEEGIAAGGVMDVNTALQEVLKTALIHDGLARGIREAAKALDKRQAHLCVLASNCDEPMYVKLVEALCAEHQINLIKVDDNKKLGEWVGLCKIDREGKPRKVVGCSCVVVKDYGKESQAKDVIEEYFKCKK Predict reactive species |
| Full Name | ribosomal protein S12 |
| Calculated Molecular Weight | 132 aa, 15 kDa |
| Observed Molecular Weight | 15 kDa |
| GenBank Accession Number | BC017321 |
| Gene Symbol | RPS12 |
| Gene ID (NCBI) | 6206 |
| RRID | AB_2146233 |
| Conjugate | Unconjugated |
| Form | Liquid |
| Purification Method | Antigen affinity purification |
| UNIPROT ID | P25398 |
| Storage Buffer | PBS with 0.02% sodium azide and 50% glycerol, pH 7.3. |
| Storage Conditions | Store at -20°C. Stable for one year after shipment. Aliquoting is unnecessary for -20oC storage. 20ul sizes contain 0.1% BSA. |
Background Information
RPS12 (ribosomal protein S12) is a plastid ribosomal protein which is a part of the 30S ribosomal subunit. Together with S4 and S5 plays an important role in translational accuracy.This antibody specifically recognizes the 15kd RPS12 protein.
Protocols
| Product Specific Protocols | |
|---|---|
| IF protocol for RPS12 antibody 16490-1-AP | Download protocol |
| IHC protocol for RPS12 antibody 16490-1-AP | Download protocol |
| IP protocol for RPS12 antibody 16490-1-AP | Download protocol |
| WB protocol for RPS12 antibody 16490-1-AP | Download protocol |
| Standard Protocols | |
|---|---|
| Click here to view our Standard Protocols |
Publications
| Species | Application | Title |
|---|---|---|
Nat Cell Biol Functional screen identifies RBM42 as a mediator of oncogenic mRNA translation specificity | ||
Mol Cell RAPIDASH: Tag-free enrichment of ribosome-associated proteins reveals composition dynamics in embryonic tissue, cancer cells, and macrophages | ||
Dev Cell Axonal endoplasmic reticulum tubules control local translation via P180/RRBP1-mediated ribosome interactions | ||
Dev Cell Progressive Differentiation and Instructive Capacities of Amniotic Fluid and Cerebrospinal Fluid Proteomes following Neural Tube Closure. | ||
Sci Signal Repurposing colforsin daropate to treat MYC-driven high-grade serous ovarian carcinomas |